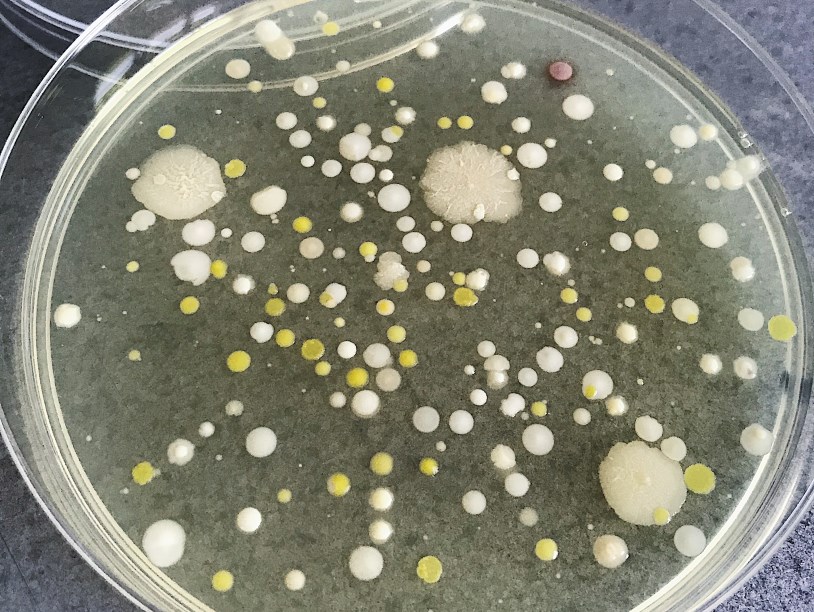

Промикробы: Микробы, они везде
В новой авторской рубрике микробиолог Екатерина Беленко показывает фотографии бактерий, с которыми она встречается в своей лаборатории, и рассказывает, чего плохого или хорошего мы можем от них ожидать.
А вы задумывались над тем, что бактерии и микроскопические грибы прямо сейчас парят в воздухе между вашим лицом и экраном? Не надо бежать за антисептиком, это абсолютно нормально, мы живем в нестерильном мире.
⠀
Одно из самых запоминающихся практических занятий курса микробиологии проходило так - на каждую пару-тройку студентов выдали чашку Петри с питательной средой и отправили в разные концы нашего учебного корпуса. Кому-то достался туалет, кто-то тусил около кабинета декана, другие пугали историков, деливших тогда с нами территорию (хотя студенты с кафедры зоологии всегда лучше справлялись с запугиванием соседей). Так вот, надо было на определенное время просто открыть крышку и подержать чашку, чтобы в неё могли «упасть» микробы. Потом поставить в термостат и идти п̶̶̶̶и̶̶̶̶т̶̶̶̶ь̶̶̶̶ п̶̶̶̶и̶̶̶̶в̶̶̶̶о̶̶̶̶ учить уроки. На следующем занятии мы с восторгом рассматривали разномастные колонии и занимались подсчетом. Если память меня не подводит, самым обсеменённым местом был вовсе не туалет, а лестница. Больше ходящих туда-сюда людей, поднимающих микробную взвесь в воздух, меньше хлорки - всё логично.
⠀
Примерно тем же самым занимается каждая бактериологическая лаборатория при больнице - не только анализами пациентов, но и санитарно-микробиологическим контролем. Для разных помещений лечебного учреждения существуют нормы микробной обсеменённости - учитывается как общее количество выросших колоний, так и отдельные представители, например, золотистый стафилококк. Даже для операционных допускается наличие микробиков, потому что создать абсолютно стерильное помещение практически невозможно. А уж в палатах, больничных коридорах, подсобных помещениях тем более. Кроме проб воздуха (кстати, у нас есть специальный аппарат, прогоняющий воздух на чашку, больше не надо просто держать её открытой и ждать) мы исследуем смывы с различных поверхностей и с рук персонала.
⠀
А особо любопытные могут подержать открытые блюдечки с паштетом или мисочки с холодцом в разных комнатах, только потом не ешьте. А на фото, как догадались самые сообразительные, как раз чашечка Петри после продувания и последующего инкубирования. Красиво, да?